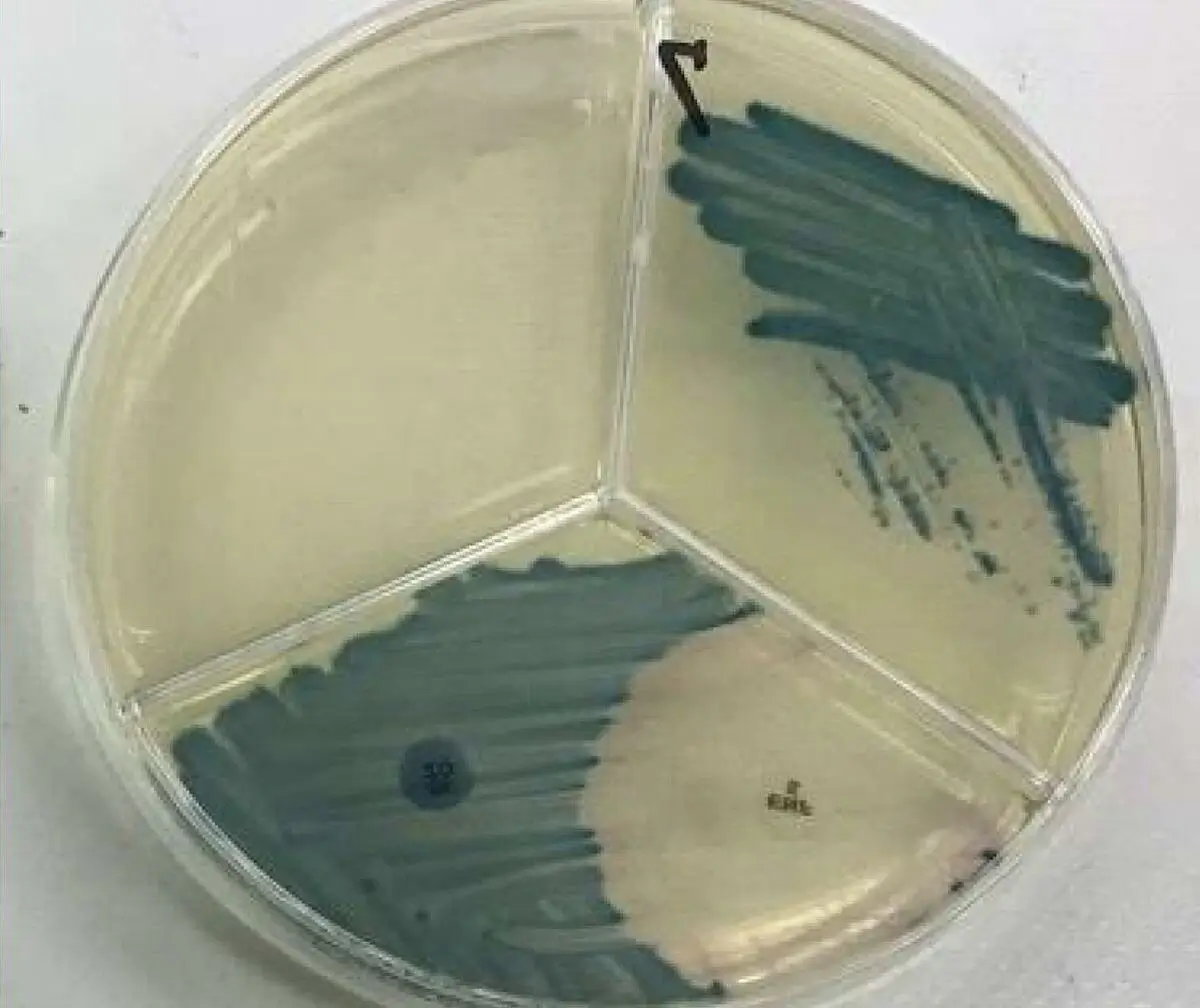

酪農学園大学獣医学類では、伴侶動物から生産動物、馬、動物園・水族館の動物、エキゾチックアニマルまで、多様な動物種を対象とした実践的な獣医学を学ぶことができます。
国内私立大学初のヨーロッパ国際認証(EAEVE)に準拠した教育システムのもと、1年生から様々な獣医職を体験できるカリキュラムで、将来の進路を見据えながら専門性を深められます。日本一の診療件数を誇る附属動物医療センターでの豊富な臨床実習、北海道という広大なフィールドでの生産動物医療、そして食の安全や国際貢献まで、獣医師として活躍できる幅広い分野を学ぶことができます。
学びながら仕事を決める
- 1年生から色々な獣医職を体験できる教育カリキュラムシステム
- 生体に限らず培養細胞や微生物を扱う様々な研究分野も学べる
- 大学内に設置されている動物愛護センターで動物福祉についても学べる
伴侶動物診療
- 国内私立大初のヨーロッパ国際認証(EAEVE)に準拠した教育システム
- 診療科と支援科が連携した「 The チーム獣医療 」
- 第一線で活躍する人材の育成
- 全国大学唯一のエキゾチック診療科
生産動物医療
- 生産動物症例数ダントツの全国1位
- 全国トップクラスの診療施設
- 学びのフィールドは酪農・畜産王国 北海道
- 全国で活躍する生産動物獣医師の出身大学シェアNo.1
馬医療
- 馬を専門に取り扱う診療科・研究室を設置している唯一の私立大学!
- 年300例以上の馬を診る唯一の私立大学!
- 日本最大の競走馬生産地、北海道日高地方へアクセスしやすい立地で、卒業生も多数馬産地にて活躍!
動物園・水族館
- 野生王国北海道の縮図、野幌原始林がキャンパスに隣接し自然豊かな環境で学べる
- ペンギン、バク、ヒグマなど、多種多様な動物園・水族館動物の診療実績あり
- 園館・エキゾ・鳥類専門医との共同研究、関連動物病院への就職実績多数
エキゾチックアニマル
- 伴侶動物は犬猫だけじゃない、まだ誰も知らない、小さな命の最前線がここにある!
- 「その検査は、犬猫にしかできない」そんな常識の限界突破への挑戦!
- 君が救いたい命は、どんなカタチ?その選択肢を日本一広くする!
食の安全を守る
- 食の安全を守るのは獣医師の重要な役割の一つ
- VRを使った食肉衛生検査実習と、全国の食肉衛生検査所と連携した、手厚いハンズオン実習
- ヒト-動物-環境で問題になっており、食の安全を守る上で重要な薬剤耐性菌に関する最先端の研究
予防獣医学 国際貢献
- 動物・人集団・環境の健康を守る ワンヘルス、予防獣医学を学べる
- WOAH(動物版WHO)指定機関で国際的な研究活動に参加し、最先端の知見に触れられる
- 卒業後は感染症予防に関わる職域(公務員等)に多数就職
生命科学研究
- 基礎研究から新しい治療法の開発が可能(動物から人まで応用可能)
- 実験動物医学専門医による指導
- 国内外との共同研究で学生も多くの賞を受賞
- 医療系大学教員や日本学術振興会研究員への採用実績あり